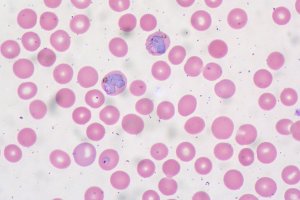

Presented By: Ecology and Evolutionary Biology
EEB Thursday Seminar: Battles in the body: within-host competition and drug resistance evolution in malaria parasites
Nina Wale, U-M EEB Postdoctoral Fellow
Drug resistant pathogens cause thousands of deaths a year and threaten our ability to treat a variety of infectious diseases, from ‘strep throat’ to malaria. Understanding which aspects of the within-host environment limit drug resistant pathogens, and how these ‘superbugs’ interact with other populations of pathogens in that environment, is vital for the development of novel, ecologically-inspired resistance management strategies. Using a malaria mouse model, we demonstrate that a nutrient limits drug resistant malaria parasites and mediates competition between drug resistant and drug susceptible parasites. We then show that manipulating the availability of such within-host nutrients can prevent the emergence of drug resistant parasites by intensifying competitive interactions between resistant parasites and their susceptible competitors. An ecological approach thus reveals an evolutionarily robust means of thwarting the emergence and spread of drug resistance.
Light refreshments served at 4 p.m.
Light refreshments served at 4 p.m.